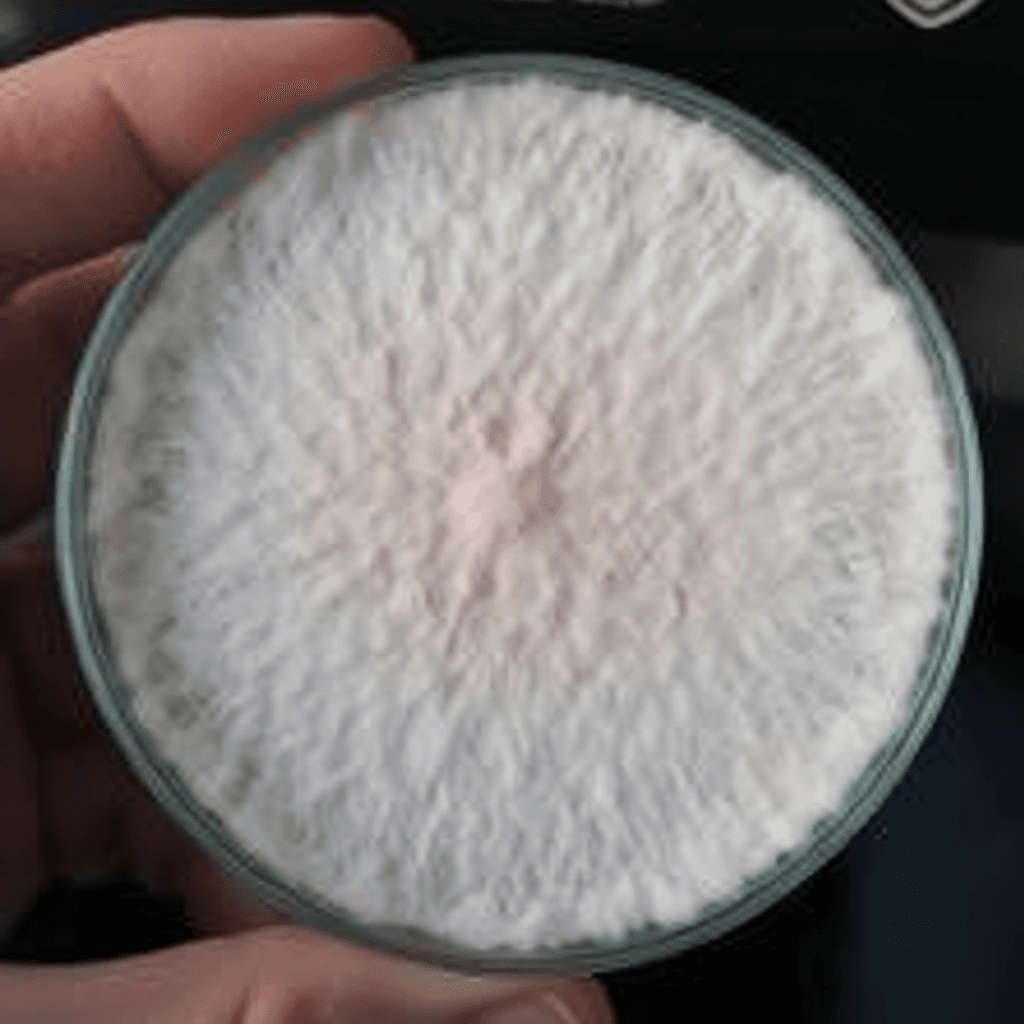
Pink Flamingo Oyster Agar Culture (NL-PJ7)
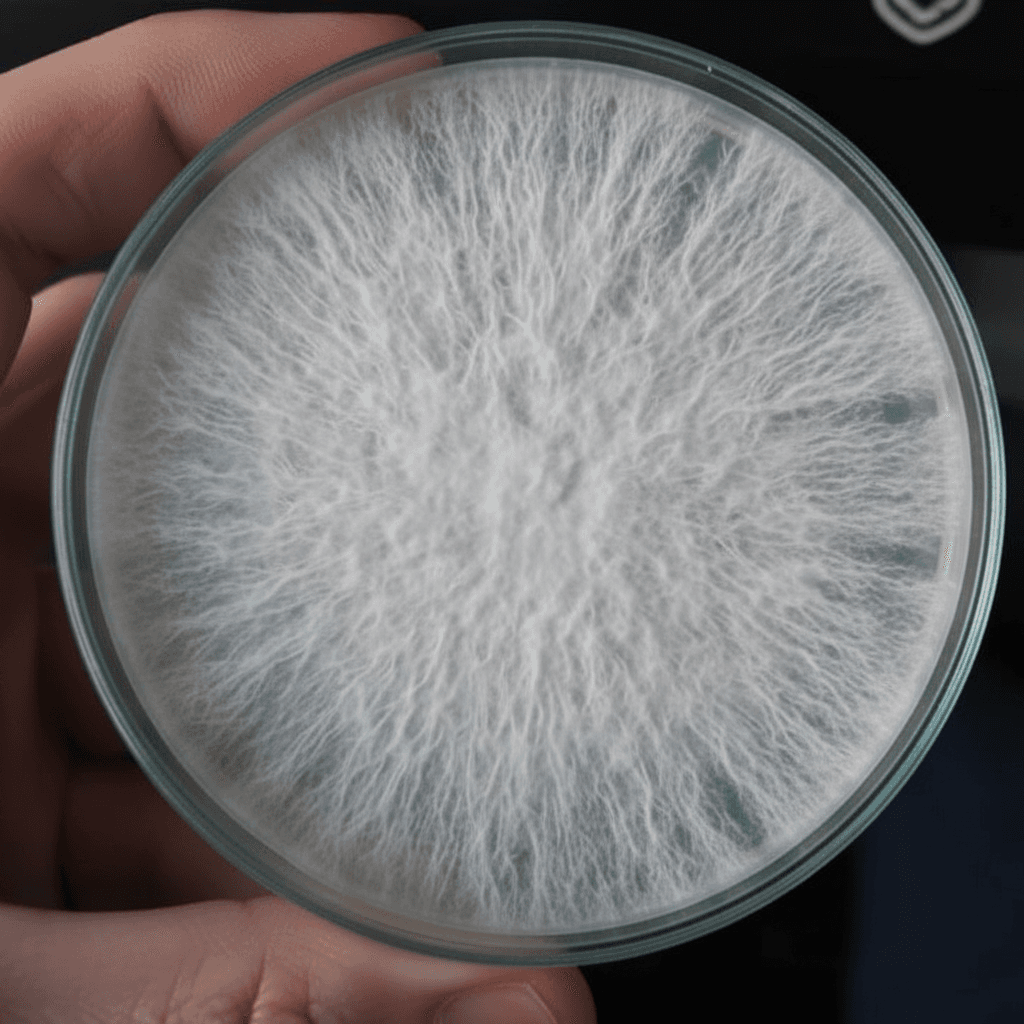
Phoenix Oyster Agar Culture (NL-PX11)

Your cart is empty

CFIA-licensed · Made in Canada · Free shipping on all orders
Ready-to-fruit kits, no experience needed
Clean energy, sharp focus
Pure Canadian-grown extracts
97 products
 50% OFF
50% OFF



 50% OFF
50% OFF 50% OFF
50% OFF


















 50% OFF
50% OFF








 50% OFF
50% OFF 50% OFF
50% OFF































 50% OFF
50% OFF













 50% OFF
50% OFF



 50% OFF
50% OFF

Nature Lion is a Canadian mushroom company producing everything in-house at our CFIA-licensed facility in Brantford, Ontario. Whether you're a commercial mushroom farmer looking for reliable grain spawn and cultivation supplies, or a home grower picking up your first grow kit, we have what you need.
Our mushroom grain spawn is produced on organic millet with lab-isolated genetics across 11 species including Lion's Mane, Blue Oyster, Pink Oyster, Shiitake, and Turkey Tail. We offer liquid cultures in both 3cc syringes for hobbyists and 200ml commercial jars for farms, plus pre-poured agar plates for culture work and strain isolation.
For those who want fresh mushrooms without the lab work, our mushroom grow kits make it easy — just open, mist, and harvest in 7 to 14 days. No equipment or experience needed. Available in Lion's Mane, Blue Oyster, Pink Oyster, Black Oyster, White Oyster, and Chestnut.
On the wellness side, we produce full-spectrum mushroom powders, tinctures, and capsules from Canadian-grown mushrooms — no fillers, no imported mycelium-on-grain. Our mushroom coffee blends combine Canadian-roasted arabica with real mushroom extract for clean energy and focus without the jitters.
Every product ships free from Brantford, Ontario. We offer free shipping on all Canadian orders and bulk pricing for commercial accounts. Contact us for wholesale inquiries, recurring orders, or custom private label production.